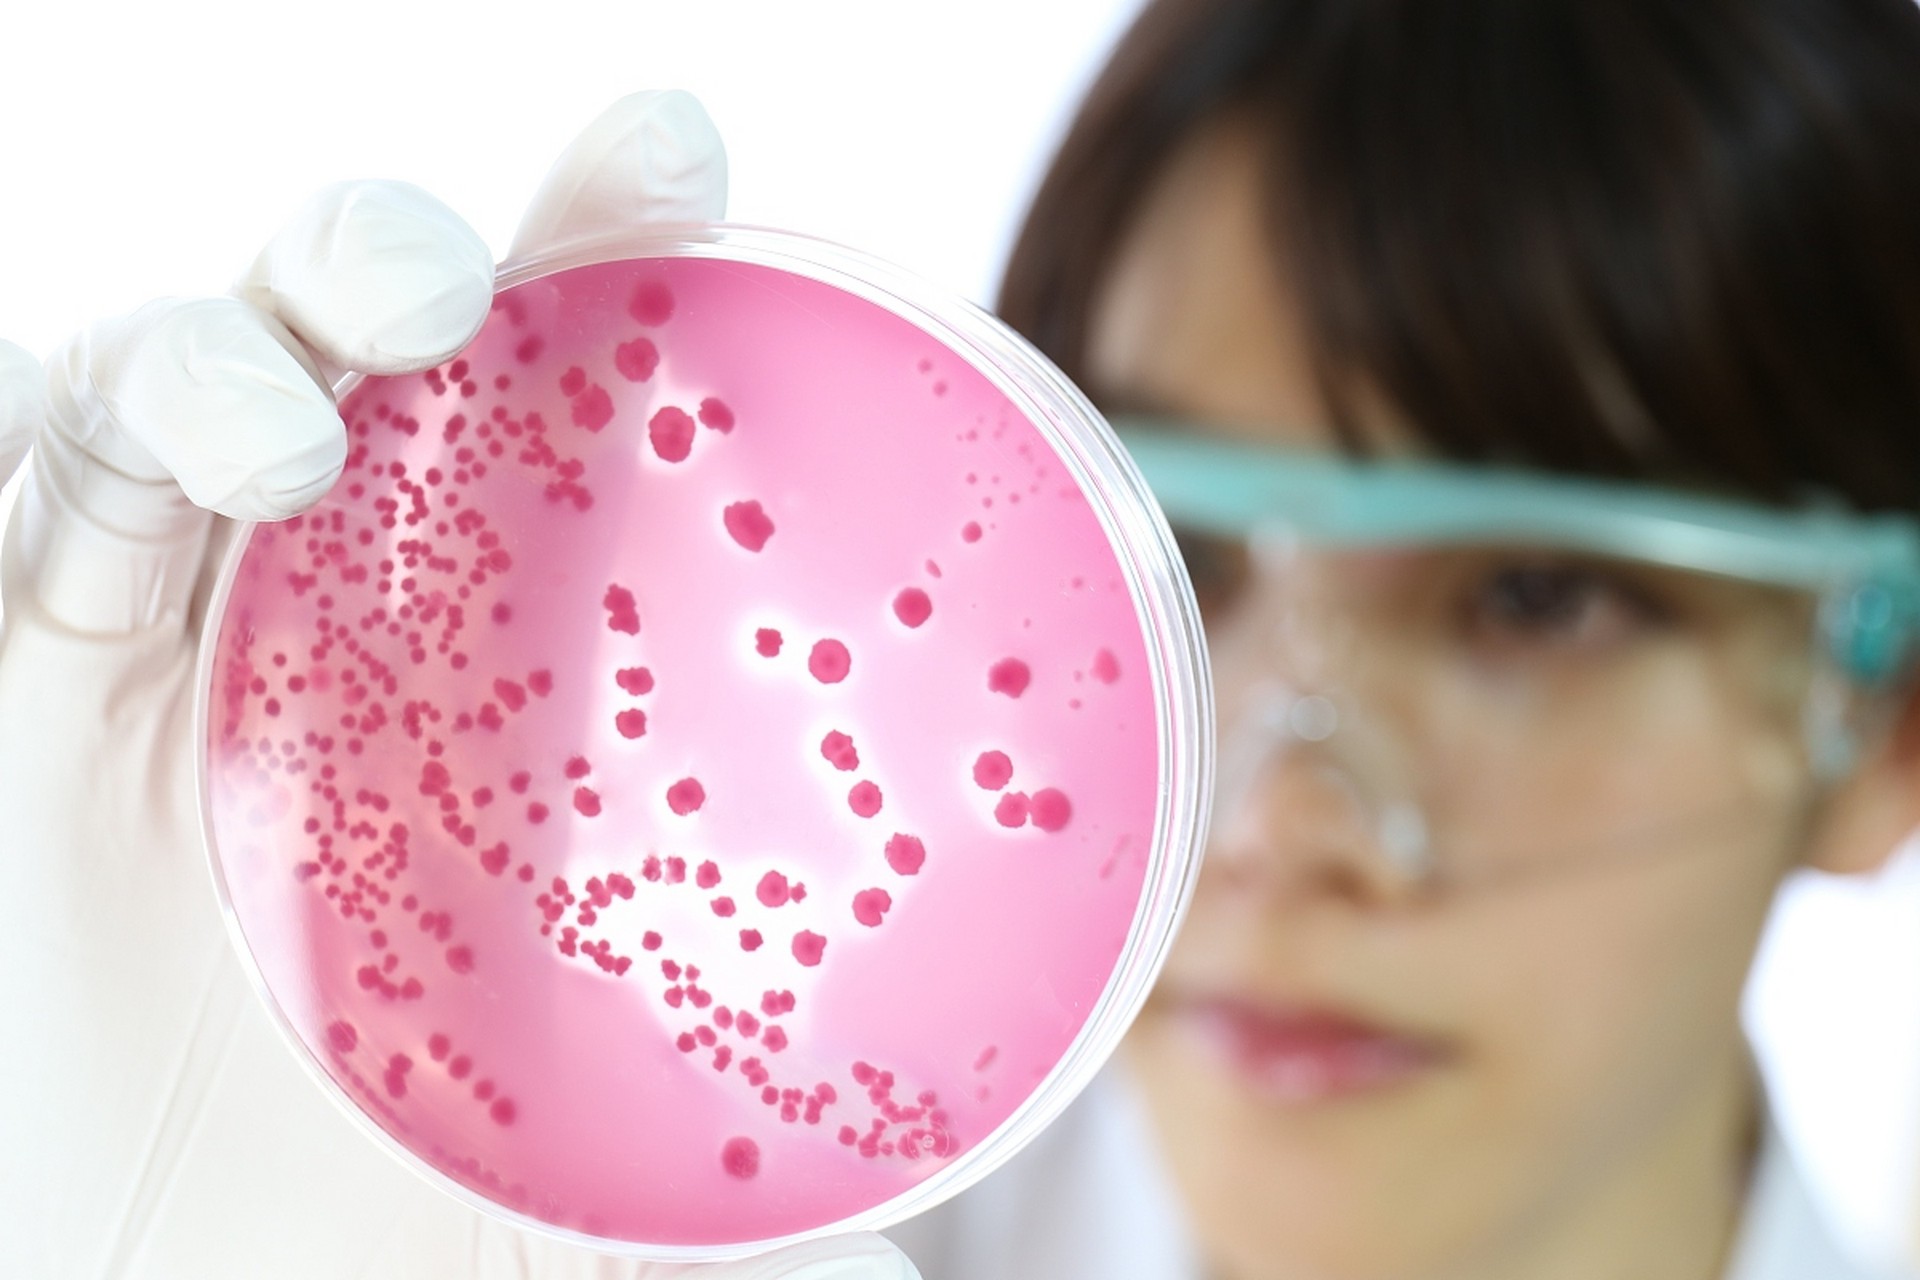

●What Is Zinc Pyrithione ?
Zinc pyrithione (ZPT), a multifunctional compound with antibacterial, antifungal, and antioxidant properties, has attracted increasing attention in recent years in the medical, cosmetic, and industrial sectors. Its unique chemical structure and wide applicability have made it an indispensable raw material in modern health and materials science.
Zinc pyrithione is composed of zinc ions bound to 2-pyridinethione-N-oxide via a coordination bond. Its molecular formula is C₁₀H₈N₂O₂S₂Zn, and its CAS number is 13463-41-7. It appears as a white to slightly yellowish crystalline powder with a high melting point of 257-259°C. It is slightly soluble in water at room temperature (approximately 8 ppm), but its solubility is lower at neutral pH, making it easier to control stability in formulations. Industrial products are typically stored as 48%-50% suspensions and should be sealed and protected from light and strong oxidants.
●What Are The Benefits Of Zinc Pyrithione ?
ZPT achieves broad-spectrum bactericidal activity (effective against 32 microorganisms) through a unique ion exchange mechanism, with a particularly low MIC of 8 ppm against Malassezia, the culprit of dandruff.
1. Antifungal And Antimicrobial Activities
Zinc pyrithione disrupts microbial cell membranes and disrupts ion gradients, inhibiting the growth of Gram-positive and Gram-negative bacteria and fungi such as Malassezia. Its MIC is as low as 8×10⁻⁶ (against Pityrosporum fumigatus), making it effective in treating fungal infections such as dandruff, seborrheic dermatitis, and athlete’s foot.
2. Antioxidant And Metabolic Regulatory Activities
Studies have shown that zinc pyrithione can increase cellular zinc levels, inhibit lipid peroxidation, and slow skin aging. In shampoo products, it can reduce scalp oil secretion and improve hair loss.
3. Anticancer Potential
Recent research has found that zinc pyrithione induces apoptosis in triple-negative breast cancer cells by targeting copper homeostasis, offering a new avenue for cancer treatment.
●What Are The Application Of Zinc Pyrithione ?
1. Daily Chemicals And Personal Care
Shampoo and Conditioner: As a core ingredient in antidandruff agents, it inhibits Malassezia and relieves scalp itching. Products containing ZPT account for over 30% of the global shampoo market and are widely used by many well-known brands.
Skin Care: Used to treat acne and eczema and regulate the skin’s microbiome.
2. Industry And Materials
Antifouling Paint: Added to marine coatings, it inhibits the attachment of barnacles and algae, reducing fuel consumption.
Antibacterial Textiles: Using nanosuspension technology to penetrate fibers, it imparts long-lasting antibacterial properties to fabrics such as cotton and polyester. It is used in medical protective clothing and sportswear.
3. Agriculture And Medicine
As a low-toxic fungicide, it prevents powdery mildew on fruit trees.
In aerosol form, it is used to treat psoriasis and pityriasis capitis, with a clinical efficacy of 80%.
●Dosage and Safety Guidelines
Daily Chemicals: Add 1.5%-2% of Zinc pyrithione to shampoo; no more than 0.5% to skin care products.
Pharmaceuticals: Apply as an aerosol spray 2-3 times daily, covering the affected area with 1ml each time. Topical concentrations should be determined according to your doctor’s instructions.
Industrial Applications: Add 0.03-0.04g/L to paints and bake at high temperatures to enhance adhesion.
Safety Tips:
Avoid contact with eyes and mucous membranes. Immediately rinse with water if contact occurs.
Long-term use at high concentrations may cause skin irritation or oxidative stress. A balance must be struck between efficacy and safety.
●Newgreen Supply High Quality Zinc Pyrithione Powder
Post time: Sep-11-2025